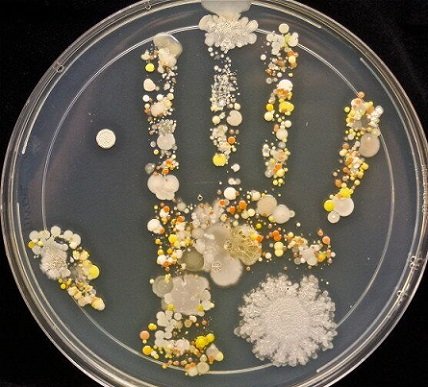

중국에서 시작된 우한 폐렴으로 전국민이 공포에 빠진 가운데

대통령이란 인간은 자국민 보호를 위해 다른 나라는 다~~~하고 있는 입국금지도 안하고.
과거 눈 뒤집고 왜 안해주냐며 손가락질하던 투명한 정보공개 등은 하나도 없으며
중국 지원에 혈세를 써대고 있는 현재

미쳐버린 정부의 행보에
자국민은 어쩔수 없이 스스로 본인의 건강을 챙겨야하는
어처구니 없는 상황이 발생했다.

일상에서 우리는 각종 세균, 바이러스 등에 그대로 노출되어있다.
휴대폰, 돈, 변기, 키보드, 엘리베이터 버튼 등
우리가 일상생활에서 눈코입 손 등을 대는 모든 환경에 세균과 바이러스 등이 존재한다.

그렇다고 이불 밖으로 안나갈 수는 없는 상황...

결국 위생과 예방을 철저하게 해서
" 우한 폐렴 코로나 바이러스 " 로 부터
스스로를 지켜내야한다.

KF - 94 이상의 마스크를 착용해야 비말형태(Droplets) 바이러스로부터 보호 받을 수 있다고 한다.
허나, 사실 감기는 손으로 전염된다는 말이 있을 정도로
우린 바이러스 감염에서 손이 가장 취약한 부분이다.

그래서 올바른 손씻기 방법과
청결을 위한 손세정제와 구분되는 손 소독제에 대해 써보도록 할까한다.
손씻기(Washing Hands)
손은 신체에서 가장 외부와의 접촉이 많은 부위이다.
대부분의 병원균이 손으로 감염된다고 봐도 무방하다.

그렇기에 올바른 손씻기는 최고의 예방법이다라고
초등학교부터 귀를 닳도록 강조를 하는 것이다.

사실 물로만 손을 씻어도 약 60%의 병원균은 씻어낼 수 있다고 한다.
비누로 손씻으면 80%의 병원균이 사라진다고 한다.

손을 씻어도 잘 안씻는 부분이 어디든 있는 법

올바른 손 씻기를 위해선
준비 : 흐르는 물에 양 손을 적신 후, 손바닥에 충분한 양의 비누를 묻혀 준다.
1. 손바닥과 손바닥을 마주대고 문질러 준다.
2. 손등과 손바닥을 마주대고 문질러준다.
3. 손바닥을 마주대고 손깍지를 끼고 문질러준다
4. 손가락을 마주잡고 문질러 준다.
5. 엄지손가락을 다른 편 손바닥으로 돌려주면서 문질러 준다.
6. 손바닥을 반대편 손바닥에 놓고 문지르며 손톱 밑을 깨끗하게 한다.
마무리 : 흐르는 물로 비눗물을 닦아내고 깨끗한 수건 혹은 핸드드라이기로 손을 건조해준다.

특히 공중화장실을 이용할 땐 손을 씻은 후 1회용 종이 타월을 이용해
손의 물기를 제거하고
병원균 감염 방지를 위해 타월로 수도꼭지를 잠궈야한다
(기껏 씻고 다시 손으로 잠그면 병원균이 또 붙음)

허나 대부분 손씻을때 그렇게 공들이는 사람이 몇이나 될까...
그래서 나온게
손소독제와 손세정제

이럴때 간편하게 병원균을 손에서 제거하는 방법이 손소독제를 이용하는 것이다.
세계보건기구 WHO에선
알코올계 손 소독제를 이용시
99.99%의 살균효과를 본다는 결과를 발표했다.

*손세정제 = 손 전용 비누
*손소독제 = 이름그대로 소독을 위해 식약처에서 허가를 받은 의약외품으로
살균 소독을 목적으로 사용되는 제품이다.
많은 사람들이 손세정제와 손소독제를 구분못하고 잘못 구매하고 있다.

손세정제는
그냥 액체형 물비누라고 생각하면된다.
주 성분은
'소듐라우레스설페이트', '코카마이도프로필베타인', '글리세린', '살리실릭액시드', '메틸클로로이소치아졸리논' 등이다.

그냥 비누처럼 물로 씻어내는 손세정제이다.

아마 여기 담당자도 손세정제와 손소독제를 혼동하고 있었을 것이다.
손소독제

손소독제는 항균효과를 주는 물질로
"물 없이" 손과 피부를 살균 소독하는 제품이다.
별도로 손을 씻거나 타월 등으로 건조할 필요가 없는 제품이다.

손소독제는 '의약외품' 으로 식약처의 심사를 통해 허가받아 나오는 제품이다.
주성분으로
'에탄올', '이소프로판올', '염화벤잘코늄', '크레졸', '과산화수소', '글리세롤' 등이다.
가끔 '초산 토코페롤' 이나 '알로에' 등을 첨가한 제품이 나오기도 한다.
> 초산 토코페롤 = 피부 거칠음 방지와 염증 억제, 항산화작용 등 효과
> 알로에 = 다들 알다시피 피부 진정효과와 염증 억제, 거칠음 방지 등 초산 토코페롤과 유사효과
손소독제의 알코올은 기본적으로 히드록시기(ㅡOH)를 달고 있다.

히드록시기는 병원균의 외투(세균의 막 or 바이러스 외피)를 구성하는
단백질 및 지질 분자들을 파괴하여
병원균이 기능을 제대로 못하도록 만든다.

판매중인 제품은
'에탄올'을 주성분으로 하는 제품과
'이소프로판올'을 주성분으로 하는 제품
2가지가 있다.
에탄올 농도가 70% 일 때 병원균에 대한 항균효과가 가장 좋다고 한다.
70%보다 농도가 높으면 병원균의 외투가 굳어 살아남을 확률이 높고
70%보다 농도가 낮으면 항균효과가 나타나지 않는다고 한다.
사실 고체 비누를 사용해 15초간 손 씻기를 할 경우
약 80%의 병원균을 제거할 수 있고
30초간 손 씻기를 할 경우
약 90%의 병원균을 제거할 수 있긴하다.

하지만 고체 비누는 사용후 물기가 남아서
병원균이 거기에 번식할 가능성이 있고
씻어내는 물 또한 오염된 물일수도 있음으로
100% 병원균 감염위험에서 안심할 수는 없다.

물의 오염 가능성
고체 비누의 오염가능성
모두를 보완한 제품이 손소독제다.
15초간 마사지하듯 문질러주면
99.99%의 병원균 살균 효과를 얻을 수 있고
세계 보건기구 WHO에서는 일반 비누보단
항균 비누 또는 손세정제를 추천하고
이보다 알코올성분 손소독제가 더 효과적이다라고 말했다.
사용법

손소독제는 물과 비누없이 살균효과를 볼 수 있는게 가장 큰 장점이다.
단, 주성분인 알코올 성분은 먼지와 기름기를 제거할 수는 없음으로
비누로 먼저 제거한 후,
손소독제로 마무리함을 추천한다.

1. 손바닥과 손바닥을 마주대고 문질러 준다.
2. 손가락등을 반대편 손바닥에 대고 문질러 준다.
3. 손바닥과 손등을 마주 대고 문질러 준다.
4. 엄지 손가락을 다른 편 손바닥으로 돌려주며 문질러 준다.
5. 손바닥을 마주 대고 손 깍지를 끼고 문질러준다.
6. 손가락을 반대편 손바닥에 놓고 문지르며 손톱 밑을 깨끗하게 한다.
주의할 점

잦은 손소독제 이용은 손 피부를 건조하게 만든다.
이걸 보안하기 위해 손소독제에
'글리세롤', '토코페놀', '알로에'를 함유시킨다.

'알로에' 등 보습제도 첨가하는데
별도로 핸드오일이나 핸드로션을 같이 사용해주는게 가장 바람직하다.
알코올은 빠르고 광범위하고 효과적인 소독력을 보여주지만
지속력이 떨어진다는 단점이 있다.
보통 일반적인 손소독제의 향균 지속시간은 1~4시간이고
손을 많이 쓰는 사람은 1~2시간마다 손소독제를 이용해주기를 추천한다.

긴 손톱이나 인조 손톱을 가지고 있는 경우
손톱아래 병원균이 남아있게 됨으로,
정말 손의 깨끗함과 몸의 건강을 생각한다면...
짧은 손톱을 권장한다.

유아는 피부가 약하고 민감함으로
일반 손소독제를 사용하면 피부에 자극을 준다.
그러므로 유아는 손소독제 사용을 피해야한다.
특히 눈, 구강, 점막, 상처가 있는 피부 등에는 닿지 않도록 주의해야한다.
눈에 들어가게되면 즉시 여러번 깨끗한 물로 씻어내야하고
사용중
'발진', '가려움증', '찌릿찌릿한 자극' 등이 있을 경우 사용을 중지하고 의사와 상담해야한다.

저품질의 손소독제를 이용시
피부에 자극을 줘서
각질과 피지도 제거하면서 손 면역력을 떨어뜨린다.
이 때문에 '습진', '태열', '아토피성 피부염' 등의 질환을 일으킬 수 있다.
따라서 제품 구매할 땐
'구성성분', '향균지속력', '보습력' 등을 확인해야한다.

손소독제는 개봉 후 내용물이 남아있는 상태에서 리필하게 되면
병원균 오염 가능성이 있으므로
사용 후
용기 재사용하지말고 그냥 폐기하길 추천한다.

대부분의 손소독제는 알코올 함량이 높아 인화성을 띄고 있다.
손소독제에 불을 붙이면 반투명 푸른 불꽃을 생성하면서
일산화탄소와 이산화탄소를 생성한다. (일산화탄소는 몸에 유해하다)
그러므로 화재 위험을 줄이고
가스중독을 막기 위해
손소독제를 발열기나 양초 등 불이 옮겨 붙기 쉬운 곳과 떨어진 곳에 보관해야한다.

전세계가 신경을 곤두세우고 재난이라고 외치고
적극적인 상황 수습을 하고 있는 현재.
이 나라 대통령은 아랫사람들에게 책임을 전가시키고 있다.
정치란,
정말 알 수 없는 것이지만
무능한 정부, 대통령, 여야 정당, 시민단체, 언론....
그저 피해는 국민만 보는 것 같습니다.
국가가 제대로 기능을 수행해주지 못하니...
나 스스로를 위해서라도
위생관리 철저히 하도록 합시다.

우한시와 신종 코로나바이러스에 대한 자세한 INFO, 상세한 증상, 치료, 예방수칙
전세계 적으로 민폐를 끼치는 중국에서 발병해 전세계를 공포로 몰아넣고 있는 우한 폐렴. 얼마전 포스팅글에서 다뤄봤는데 날이 갈수록 심각해져감에 좀더 자세히 다뤄봤습니다. 우한 폐렴 감염시작, 증상, 치료..
2itooit.tistory.com
코비 브라이언트(Kobe Bryant)에 대한 INFO
은퇴한 마이클 조던의 뒤를 잇는 2000년대 최고의 슈팅가드 코비 빈 브라이언트(Kobe Bean Bryant)가 헬기로 이동하던중 오늘 추락사고로 사망하였습니다. 1978년 8월 23일 필라델피아 출생 ~ 2020년 1월 26일..
2itooit.tistory.com
타우린(Taurine) 그게 대체 뭐길래?
타우린이란 이름은 황소를 뜻하는 라틴어 타우루스Taurus에서 나왔다. 1827년 오스트리아 화학자 프리드리히 티드만(Friedrich Tiedemann), 레오폴트 그멜린(Leopold Gmelin)은 소의 담즙에서 최초로 타우린 분리..
2itooit.tistory.com
달(Moon)에 대한 꼼꼼한 INFO
요즘 INFO글을 많이 못쓰고 있어서 고민이 많았는데 유튜브 우주관련 영상을 많이 보다보니 흥미로운 정보를 많이 찾아서 달에 관해 한번 써볼까해요! 과거에는 지구상의 떨어진 두 지점에서 동시에 달의 위치..
2itooit.tistory.com
[국어](문법)(단어편)단어의 분류 1 - 체언, 관계언
여러분!!! 안!녕! 투잇이야 그만뒀던 영화관 알바를 최근에 다시 입사하게 되어서ㅋㅋㅋ 하루 늦어버린점 미안해 ㅠㅠ 지난번 국어 문법 단어편, 단어의 형성에서 형태소에 대해 배워봤어 자립 형태소, 의존 형태..
2itooit.tistory.com
[국어](문법)(단어편) 단어의 형성
지난번 음운변동 마지막편 ↓ [국어](문법) 탈락(자음군 단순화, ㅎ탈락, ㅡ탈락), 첨가(ㄴ첨가), 축약(거센소리되기, 모음축약) 여러분 안녕!?최근 포스팅한 문법 내용들이야복습이 필요하거나 궁금한것..
2itooit.tistory.com
[국어](문법) 자음
지난번에 모음에 대해 알아봤어 [국어](문법) 음운 체계 (1) 모음 - 단모음 [국어](문법) 음성 vs 음운 문법을 공부하다보면? 수능 국어를 공부하다보면, LEET 국어를 공부하다보면, 정말 수많은 국어 시험 갈래..
2itooit.tistory.com
[루머] 김유정 BTS 뷔 열애?! 지하철데이트 팬덤사이에선 거의 확실시...
얼마전 BTS 뷔 님이 지하철 인증을 하셨죠 다들 왜 지하철 갑자기 탐? 한번 타보고싶었나? 특이해~ 이런 반응이었는데 얼마후 배우 김유정씨 SNS에 사진이 올라옵니다 팬덤들은 건대역 내선순환 2호선인걸 포..
2itooit.tistory.com
[국어](문법) 음성 vs 음운
문법을 공부하다보면? 수능 국어를 공부하다보면, LEET 국어를 공부하다보면, 정말 수많은 국어 시험 갈래들을 공부하다보면 음운이란게 기본적으로 나온다. '대치'는 한 음운이 다른 음운으로 변하는 현상이야~..
2itooit.tistory.com
대통령도 복용하고 있다는 아스피린에 대한 INFO
고대 이집트 시대부터 진통 해열제로 사용되었단 기록이 있는 아스피린(ASPIRIN) 얼마전까지 항암효과까지 있단 소식에 만병통치약이구나!!!하며 불렸지만 그 약효를 두고 연구결과와 의견들이 나뉘어 지고 있는..
2itooit.tistory.com
아이폰SE2 출시일!!! & 깜빡할 수 있는 애플케어플러스 꿀팁
아이폰SE2 기다리시는 분들이 엄청 많을겁니다. 하지만 매년 SE2 나온다 나온다 해놓고 진짜 1도 안나오는 경우가 너무 많았습니다. 항상 루머뿐인 넌....정말 노답 ㅠ 아이폰 SE 의 그 각진 디자인... 아이패드..
2itooit.tistory.com
구글의 미래에 대한 투자 INFO
티스토리 블로그를 열면서 에드센스를 달아볼까? 하며 이것저것 알아보던 와중 구글의 엄청난 공격적이면서도 다방면으로 투자하는 여러 미래지향적 회사들이 많다는걸 알고 거기에 대해 한번 이야기 해볼까합니..
2itooit.tistory.com
'INFO 정보' 카테고리의 다른 글
| 2020년 2월 기준 고용 보험 조회 방법, 이직확인서 처리여부 조회 방법 (0) | 2020.02.05 |
|---|---|
| 네이버 애드포스트 신청에서 승인까지 INFO (0) | 2020.02.05 |
| 신종 코로나바이러스 자세한 정보, 상세한 증상, 치료, 예방수칙 (0) | 2020.01.29 |
| 수익형 블로그? 애드센스, 애드포스트. 티스토리와 네이버 블로그, 애드센스 승인기1 INFO (0) | 2020.01.28 |
| 코비 브라이언트(Kobe Bryant)에 대한 INFO (0) | 2020.01.27 |
댓글